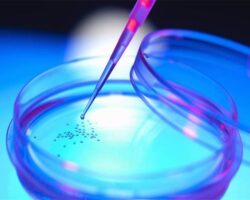

جستجوی اخبار
عضویت در سایت

فهرست اخبار و تازه ها
کشف ژن های مرتبط با آلزایمر و سندروم داون
یافته جدید پزشکی محققان بریتانیایی؛ کشف ژن های مرتبط با آلزایمر و سندروم داون محققان یک گام به شناسایی ژن های مسئول ابتلا زودهنگام بیماران مبتلا به سندروم داون به ...
بیشتر بخوانید طراحی الگوریتم برای جلوگیری از متاستاز سرطان
طراحی الگوریتم برای جلوگیری از متاستاز سرطان تهران– ایرنا– محققان از یک الگوریتم محاسباتی برای ردیابی گسترش سلول های سرطانی استفاده کردند.به گزارش گروه اخبار علمی ایرنا از پایگاه خبری ...
بیشتر بخوانید پایان مردادماه آخرین مهلت ثبتنام چهارمین جشنواره و نمایشگاه گیاهان دارویی؛
پایان مردادماه آخرین مهلت ثبتنام چهارمین جشنواره و نمایشگاه گیاهان دارویی؛ علاقهمندان و فعالین تا پایان مردادماه برای ثبتنام چهارمین جشنواره و نمایشگاه گیاهان دارویی، فرآوردههای طبیعی و طب ایرانی ...
بیشتر بخوانید امحای سلول های سرطانی با نانوذرات مغناطیسی
امحای سلول های سرطانی با نانوذرات مغناطیسی تهران– ایرنا– محققان موفق به تولید نوع جدیدی از نانوذرات شده اند که به سلول های سرطانی نفوذ کرده، آنان را داغ می ...
بیشتر بخوانید ماسک معطر دارویی با خاصیت درمان سرماخوردگی تولید شد
توسط محققان کشور؛ ماسک معطر دارویی با خاصیت درمان سرماخوردگی تولید شد محققان دانشکده مهندسی نساجی در دانشگاه صنعتی امیرکبیر موفق به طراحی ماسک های معطر دارویی با خاصیت رهایش ...
بیشتر بخوانید دستیابی محققان ایرانی به سلول های زمینه ساز درمان پارکینسون
دستیابی محققان ایرانی به سلول های زمینه ساز درمان پارکینسون تهران-ایرنا- مدیر مرکز مغز و علوم شناختی پژوهشگاه رویان گفت: محققان ایرانی در راستای سلول درمانی بیماری پارکینسون، توانستند به ...
بیشتر بخوانید فناوری هوش مصنوعی به درمان دیابت شتافت
فناوری هوش مصنوعی به درمان دیابت شتافت تهران- ایرنا- محققان دانشگاه واترلو در کانادا، با استفاده از فناوری رادار و هوش مصنوعی سیستمی طراحی کردند که مبتلایان به دیابت را ...
بیشتر بخوانید درمان زخم های دهان با بانداژ جدید
درمان زخم های دهان با بانداژ جدید تهران – ایرنا - محققان دانشگاه شفیلد انگلیس بانداژ جدیدی را ساختند که به درون دهان می چسبد و با رهاسازی دارو عوارضی ...
بیشتر بخوانید گیاهان دارویی ایران هرکدام به مثابه یک چاه نفت ارزشمند هستند.
عضو هیئت علمی پژوهشکده گیاهان دارویی جهاد دانشگاهی: گیاهان دارویی ایران هرکدام به مثابه یک چاه نفت ارزشمند هستند. عضو هیئت علمی پژوهشکده گیاهان دارویی جهاد دانشگاهی گفت: کشور ما ...
بیشتر بخوانید ساخت ضربان سازی که کنار قلب قرار می گیرد
ساخت ضربان سازی که کنار قلب قرار می گیرد تهران – ایرنا – محققان بیمارستان کودکان لس آنجلس و دانشگاه کالیفرنیای جنوبی موفق به ساخت یک میکرو پِیس میکر (ضربان ...
بیشتر بخوانید